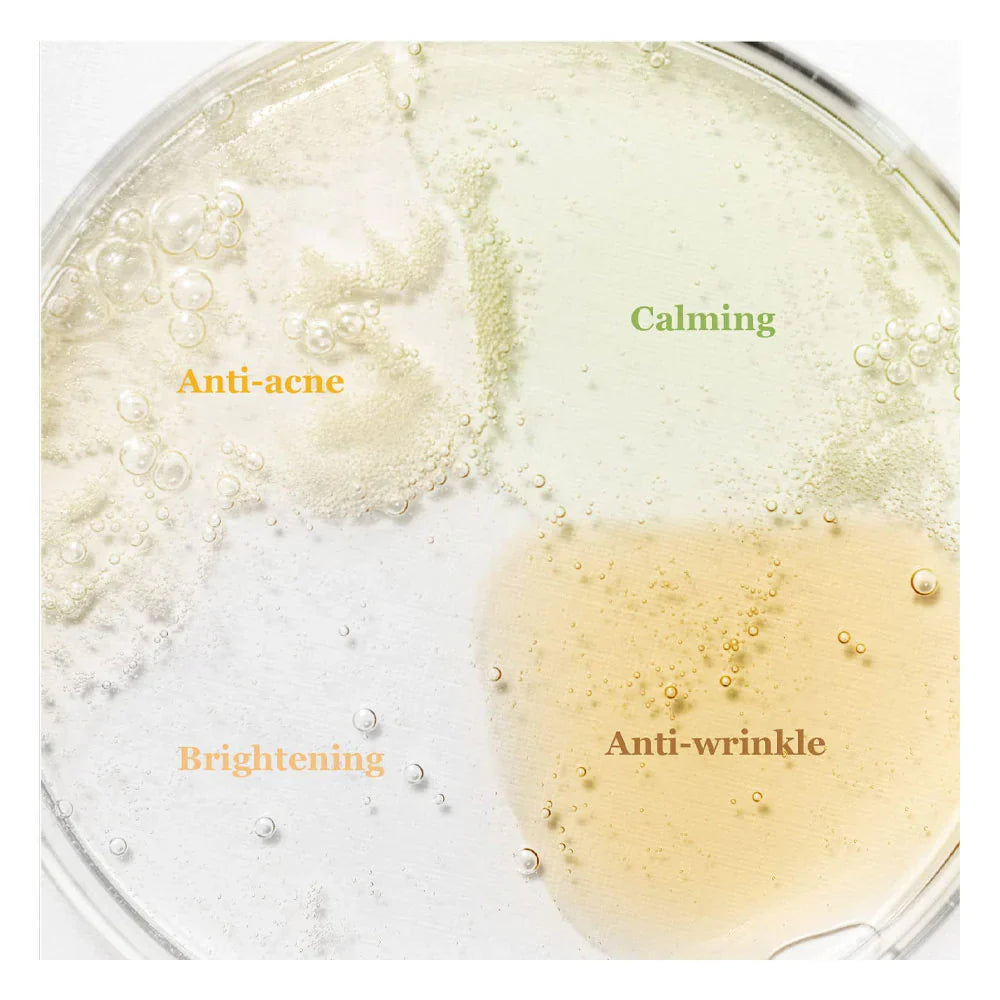
Hanbang Serum Discovery Kit - Reduce irritación

Hanbang Serum Discovery Kit - Reduce irritación
Pague de forma segura con IDEAL u otros métodos de pago.
Descripción
Descripción
Beauty of Joseon Hanbang Serum Discovery Kit es un set de mini sérums pensado para que puedas probar los cuatro sérums más populares de la marca. Cada uno está formulado con ingredientes herbales tradicionales (hanbang) y activos modernos para tratar diferentes necesidades de la piel.
Contenido del kit
Incluye 4 sérums de 10ml cada uno:
1. Glow Serum – Propolis + Niacinamide
- Ilumina y calma la piel
- Reduce rojeces y mejora la textura
- Ideal para piel apagada o sensible
2. Calming Serum – Green Tea + Panthenol
- Reduce irritación y rojeces
- Refuerza la barrera cutánea
- Perfecto para piel sensible o reactiva
3. Revive Serum – Ginseng + Snail Mucin
- Nutre y mejora la elasticidad
- Suaviza líneas finas
- Ideal para piel madura o deshidratada
4. Glow Deep Serum – Rice + Alpha-Arbutin
- Ayuda a aclarar manchas y unificar el tono
- Aporta luminosidad suave
- Ideal para piel con hiperpigmentación
Beneficios del kit
- Permite probar los 4 sérums antes de comprar el tamaño grande
- Ideal para viajes
- Fórmulas suaves aptas para piel sensible
- Cada sérum cubre una necesidad distinta
Modo de uso
- Aplicar 2–3 gotas del sérum elegido sobre la piel limpia.
- Masajear suavemente hasta su absorción.
Compra hoy, recíbelo en 3–4 días
Compra hoy, recíbelo en 3–4 días
Haz tu pedido antes de las 19:00 y nos aseguraremos de que tus productos favoritos de K‑beauty lleguen en un plazo de 3 a 4 días. Trabajamos con servicios de entrega fiables, pero claro, a veces el tráfico o el clima no ayudan.
En casos excepcionales, la entrega puede tardar un poco más.Pase lo que pase, te mantendremos informado para que siempre sepas dónde está tu pedido.
¡Rápido, sin complicaciones y enviado con mucho cariño!
Devoluciones fáciles en 60 días
Devoluciones fáciles en 60 días
K-Beauty sin el estrés de elegir
Queremos que pruebes nuestros productos con confianza: por eso en Kateo-Beauty tienes 60 días para cambiar de opinión.
Ya sea que estés indeciso sobre qué tónico usar o que esa esencia simplemente no sea de tu agrado, no te preocupes .
Las devoluciones son fáciles y sin complicaciones dentro de los 60 días posteriores a la recepción. Así, podrás descubrir el mundo del cuidado de la piel coreano a tu propio ritmo.
Porque la belleza no sólo se trata del exterior, sino también de una experiencia de compra sin preocupaciones .
Comparte más




¿Tienes alguna pregunta sobre este producto?
Notified by email when this product becomes available

€23,90
Recommended products

Ligero como el aire, poderoso como siempre.
Este producto contiene 10 tipos de Ácido Hialurónico , que van desde alto a ultra bajo peso molecular , diseñados para hidratar profundamente, suavizar y refinar la piel, haciéndola lucir mucho más joven.
Recently viewed product
Subscribe to our emails
Regístrate: ¡tu piel te lo agradecerá (y tu espejo también)!